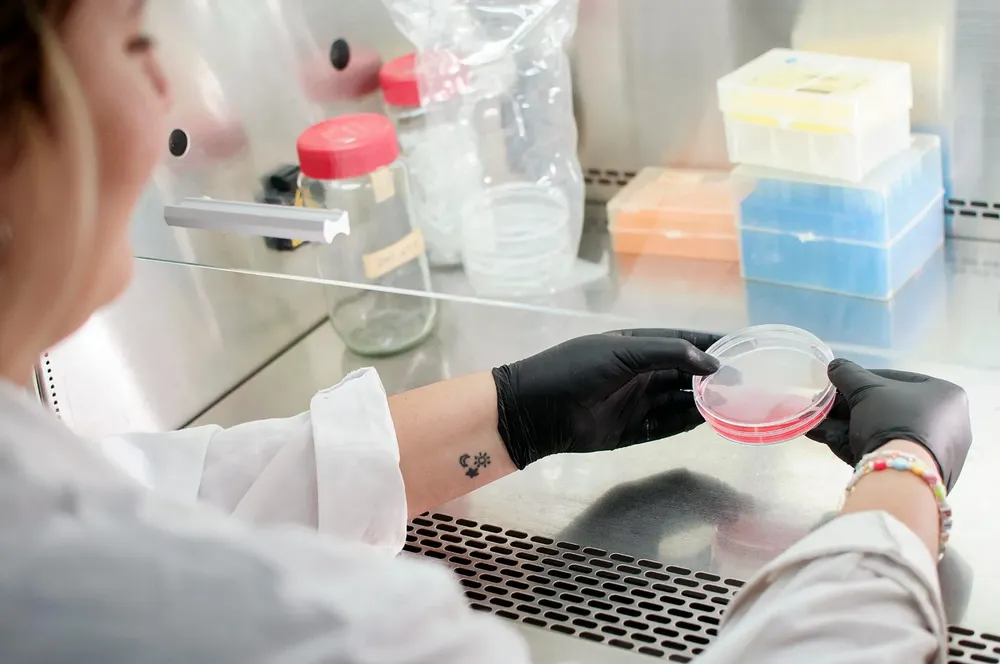
14 a

Ex ministro de Transporte bonaerense se presentó ante el fiscal de La Plata por el fraude con la VTV
REGIÓN16/12/2025Jorge D’Onofrio negó las acusaciones. Presentó un escrito. Buscan esclarecer la oscura trama entre abogados y funcionarios que habrían operado para reducir o anular multas de tránsito a cambio de pagos ilegales.